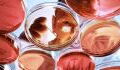
Staphylokokken: Ansteckung, Symptome und Behandlung

Was ist Grippe?
Bei der Grippe handelt es sich um eine sehr verbreitete und äußerst ansteckende Krankheit: Jedes Jahr im Winter erkranken tausende Deutsche daran. Auch wenn die Intensität dieser Herbst-Winterepidemie von Jahr zu Jahr unterschiedlich ausfällt, waren im vergangenen Jahr mit 300.000 gemeldeten Fällen besonders viele Menschen betroffen.
Influenza, wie diese Erkrankung auch genannt wird, wird von drei Viren verursacht, die alle von der gleichen Familie und der gleichen Art (dem Influenzavirus) abstammen. Diese Mikroorganismen greifen die Atemwege an und sorgen für ein allgemeines Unwohlsein.
Welche Symptome weisen auf eine Grippe hin?
Eine Grippeinfektion geht mit mehreren Symptomen einher, die nach einer Inkubationszeit von etwa 24 bis 48 Stunden auf meist heftige Weise auftreten. Die betroffenen Personen leiden zum Beispiel unter:
- Schüttelfrost
- Muskel- und Gliederschmerzen
- Starker Müdigkeit
- Starken Kopfschmerzen, vor allem im Stirnbereich
- Halsschmerzen
- Hohem Fieber, häufig über 38,5 °C
- Lichtempfindlichkeit
- Erhöhter Herzfrequenz (Tachykardie)
- Schluckbeschwerden (Dysphagie)
- Schwierigkeiten beim Sprechen
- Laufender Nase
Die respiratorischen Beschwerden können außerdem mit trockenem Husten, laufender oder verstopfter Nase sowie Appetitlosigkeit einhergehen. Die Symptome können zwischen 24 Stunden und etwas länger als einer Woche anhalten. Bei ersten Anzeichen sollte unbedingt ein Arzt aufgesucht werden, um die Diagnose zu bestätigen oder zu widerlegen.
Und für alle, die gar nicht erst auf die Symptome warten wollen, hier wertvolle Tipps, wie ihr eine Grippe vermeidet!